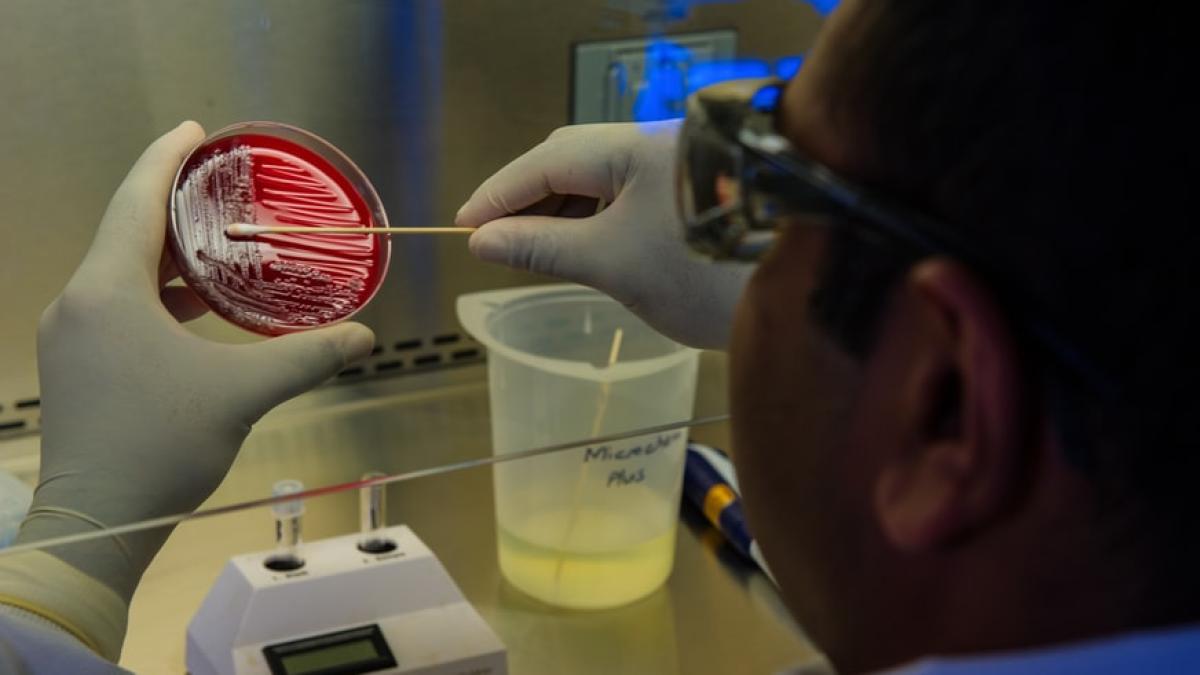
laborator_96374300

Ceea ce este cel mai important acum este ce poate face fiecare dintre noi la nivel personal, luare măsurilor care și cerând acțiuni eficiente din partea liderilor mondiali.
Rapoartele conform cărora majoritatea cazurilor de omicron sunt ușoare sunt, în mod normal, liniștitoare pentru multe persoane - în special pentru cei dintre noi care nu sunt în vârstă sau imunocompromiși și care au acces la vaccinuri de rapel. Dar unii oameni de știință sunt nemulțumiți în fața unui astfel de optimism din cauza imaginii mai largi. Dacă acest lucru continuă să crească exponențial și infectează milioane de oameni într-un timp scurt, sistemele de sănătate se vor prăbuși, chiar dacă o fracțiune mai mică de cazuri sunt grave.
Cazurile cresc rapid în Marea Britanie și în Africa de Sud, sugerând că omicron are un oarecare avantaj față de delta, varianta dominantă în prezent a coronavirusului. S-ar putea ca acesta să fie mai transmisibil în mod inerent, sau că este mai capabil să treacă mai ușor de imunitatea celor care au fost infectați sau vaccinați, sau o combinație a acestor doi factori, notează Bloomberg.
Ce știm la ora actuală
Genele variantei Omicron sunt ciudat de diferite față de variantele anterioare, părând a fi doar înrudite în mod îndepărtat cu delta. Nimeni nu este sigur de unde provine - posibil să se fi dezvoltat timp de luni de zile în pacienți cu imunitate compromisă sau să fi sărit într-o gazdă animală și apoi înapoi la oameni.
Are 21 de mutații în partea superioară a proteinei spike, a declarat într-un interviu epidemiologul molecular Emma Hodcroft de la Universitatea din Berna. Unele dintre aceste mutații sunt alarmante, deoarece au fost observate în variantele anterioare, care permiteau evitarea imunității vaccinale sau de la infecții anterioare.
În doar câteva săptămâni, oamenii de știință au acumulat o cantitate impresionantă de date preliminare. Unele laboratoare au asamblat versiuni simulate ale omicron prin manipularea genetică a altor variante pentru a purta unele dintre mutațiile cheie ale acestei variantei, a spus Hodcroft. Cercetătorii pot cultiva acești "pseudovirusuri" în laborator și pot testa cât de bine rezistă la anticorpii extrași din sângele persoanelor vaccinate sau infectate anterior.
Omicron, încoronat REGELE mutațiilor. Concluziile primului studiu
OMICRON. Atenție! Este un SIMPTOM care apare în special la COPII
Date preliminare despre OMICRON. Anthony Fauci face precizări
Știrea care a speriat lumea cu adevărat
Apoi, săptămâna trecută, un laborator din Africa de Sud a ținut prima pagină a ziarelor cu rezultatele privind comportamentul unor mostre reale de omicron. Studiul a constatat că virusul a reușit să eludeze într-o oarecare măsură imunitatea generată de două injecții cu vaccinul Pfizer, dar a fost neutralizat bine de anticorpii extrași de la pacienții care fuseseră atât vaccinați, cât și infectați anterior cu variantele anterioare. Aproximativ în același timp, Pfizer a anunțat că anticorpii de la o injecție de rapel au ajutat la stoparea omicron în experimentele de laborator, deși rezultatele nu au fost revizuite de colegi, iar cercetătorii externi nu au apucat să vadă datele.
În cadrul unei conferințe de presă de miercuri, specialistul în boli infecțioase de la Harvard, Yonatan Grad, a declarat că încă nu se cunosc detalii despre niciunul dintre aceste experimente. Sângele provine de la persoane care au fost vaccinate luna trecută sau acum 10 luni? Acest lucru contează deoarece alte studii au demonstrat că anticorpii din vaccinurile Pfizer și Moderna se diminuează semnificativ după șase până la nouă luni.
"În viața reală, s-ar putea să fie mai complex, dar cred că putem spune probabil că ne așteptăm la mai multe reinfecții sau infecții descoperite cu omicron decât am văzut cu alte variante", a spus Hodcroft.
Ce nu se știe
Cât de grave vor fi aceste infecții nu este clar. Vaccinurile (sau infecțiile din trecut) lasă la oameni celule imunitare care se ascund în măduva osoasă și în ganglionii limfatici, iar acestea se activează dacă există o nouă infecție și creează o mulțime de anticorpi noi. Experimentele de laborator nu ar surprinde neapărat acest fenomen.
Cum și unde se răspândește boala va depinde de cazurile anterioare din populație, de absorbția vaccinului, de ciclurile sezoniere și de alți factori pe care nimeni nu îi înțelege încă. Comportamentul din trecut a fost surprinzător.
Variantele anterioare, inclusiv alfa, au crescut rapid în estul SUA în toamna anului 2020 și apoi s-au prăbușit în mijlocul iernii 2021. Aceste variante timpurii abia au atins India, dar delta a explodat brusc acolo în primăvara anului 2021. Și acel val a avut o vârf după care a scăzut brusc.
În cazul omicron, gravitatea bolii va fi deosebit de greu de stabilit fără a aștepta până când va infecta un număr considerabil de persoane de vârste diferite.
Variantele de lucru
"Chiar dacă Omicron are o severitate mai blândă - și nu știm acest lucru în acest moment - dacă se răspândește foarte repede, chiar și un procent mai mic dintr-un număr mare este un număr mare", a spus Hodcroft. "Suntem, de asemenea, în cea mai mare parte a vestului, destul de prost pregătiți pentru acest lucru, deoarece cazurile noastre delta sunt atât de ridicate - avem foarte puțin spațiu de manevră rămas."
Așadar, cel mai bun scenariu ar fi fie că omicronul nu este atât de transmisibil pe cât părea la început și se stinge, fie că este doar puțin mai transmisibil decât delta și mult mai ușor - atât de ușor încât aproape nimeni nu trebuie să fie internat la terapie intensivă.
"Ar fi cel mai bun lucru la care putem spera", a spus Hodcroft, dar nu este un lucru pe care ea sau alți experți pariază.
Speranța este în regulă atâta timp cât nu îi adoarme vigilența oamenilor. Se pot face multe acum, inclusiv producerea de vaccinuri specifice omicron și o mai bună distribuire a vaccinurilor existente către țările care au cea mai mare nevoie de ele. Oamenii trebuie să fie pregătiți pentru mai multe restricții în cazul în care scenariile cele mai pesimiste se adeveresc.
Există unele dovezi că vaccinările reduc transmiterea. Asta înseamnă că, cu cât mai mulți oameni sunt vaccinați în întreaga lume, cu atât sunt mai puține șanse ca virusul să sufere noi mutații ducând la noi variante - ceva care nu este deloc ușor.